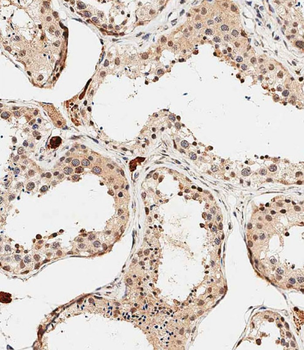
PDCD4 Antibody (Center)

You have no items in your shopping cart.
Pdcd4 Antibody
Description
Images & Validation
−| Tested Applications | ELISA, IHC, WB |
|---|---|
| Dilution Range | ELISA: 1:10,000 - 1:100,000, IHC: 1:100 – 1:300, WB: 1:1,000 - 1:10,000 |
| Reactivity | Human, Mouse |
| Application Notes |
Key Properties
−| Antibody Type | Primary Antibody |
|---|---|
| Host | Rabbit |
| Clonality | Polyclonal |
| Isotype | IgG |
| Immunogen | This affinity purified antibody was prepared from whole rabbit serum produced by repeated immunizations with a synthetic peptide corresponding amino acids near the carboxyl terminus of human Pdcd4 protein. |
| Purity | This affinity purified antibody is directed against human Pdcd4 protein. The product was affinity purified from monospecific antiserum by immunoaffinity chromatography. A BLAST analysis was used to suggest cross-reactivity with Pdcd4 from human, mouse, rat and Xenopus based on 100% homology with the immunizing sequence. Cross-reactivity with Pdcd4 from other sources has not been determined. The antibody reacts with Pdcd4 protein that is either phosphorylated or non-phosphorylated at Ser457. |
| Conjugation | Unconjugated |
Storage & Handling
−| Storage | Store vial at -20° C prior to opening. Aliquot contents and freeze at -20° C or below for extended storage. Avoid cycles of freezing and thawing. Centrifuge product if not completely clear after standing at room temperature. This product is stable for several weeks at 4° C as an undiluted liquid. Dilute only prior to immediate use. |
|---|---|
| Form/Appearance | Liquid (sterile filtered) |
| Buffer/Preservatives | Preservative: 0.01% (w/v) Sodium Azide. Stabilizer: None; Buffer: 0.02 M Potassium Phosphate, 0.15 M Sodium Chloride, pH 7.2 |
| Concentration | 1.0 mg/mL |
| Expiration Date | 12 months from date of receipt. |
| Dry Ice Shipping | Please note: This product requires shipment on dry ice. A dry ice surcharge will apply. |
| Disclaimer | For research use only |
Alternative Names
−Similar Products
−Phospho-PDCD4 (Ser67) Rabbit Polyclonal Antibody [orb312714]
FC, ICC, IF, IHC-Fr, IHC-P
Bovine, Canine, Equine, Gallus, Porcine, Rabbit, Sheep
Human, Mouse, Rat
Rabbit
Polyclonal
Unconjugated
100 μl, 50 μl, 200 μlPDCD4 Antibody (Center) [orb1936226]
IHC-P, WB
Human, Mouse, Rat
Rabbit
Polyclonal
Unconjugated
100 μl, 50 μl

Quality Guarantee
Explore bioreagents carefree to elevate your research. All our products are rigorously tested for performance. If a product does not perform as described on its datasheet, our scientific support team will provide expert troubleshooting, a prompt replacement, or a refund. For full details, please see our Terms & Conditions and Buying Guide. Contact us at [email protected].

Affinity purified anti-Pdcd4 was used at a 1:100 dilution to detect Pdcd4 by immunohistochemistry on mouse colon tissue. Tissue was fixed in 4% paraformaldehyde and paraffin embedded. Tissue sections were deparaffinized and treated by trypsinization before staining.

ERK8 phosphorylates HuR to prevent its binding to PDCD4 mRNAA. ERK8 or control siRNA was transfected into HeLa cells for 48 h followed by treatment of cells with 0.5 mM H2O2 or PBS for 1 h. Cells were fixed and immunofluorescence was performed to monitor HuR localization. Hoechst was used to stain the nuclei. Nuclear/Cytoplasmic ratio of HuR is shown on the right. Higher ratio denotes more nuclear staining. B. Top panel: HeLa cells were treated as in (A) and cells were harvested for western blot analysis for indicated proteins. Bottom panel: Quantification of PDCD4 protein levels relative to Tubulin. C. The kinase assay was performed with immunoprecipitated Flag-HuR or Flag empty vector as substrate and HA-ERK8 kinase in the presence of 32P gamma-ATP and exposed to X-ray film. The levels of HuR and ERK8 proteins were detected by western blot analysis.

H2O2 causes cytoplasmic accumulation of HuR and a loss in PDCD4 expression that is mediated by miR-21A. HuR localization by immunofluorescence of HeLa cells treated with PBS (0 mM H2O2) or 0.5 mM H2O2 for 1 h. Nuclei are visualized by Hoechst staining. Nuclear/Cytoplasmic ratio of HuR is shown on the right. Higher ratio denotes more nuclear staining. B. Left panel: HeLa cells were treated with 0.5 mM H2O2 for the indicated times and cell lysates analysed by western blot analysis indicating a decrease in PDCD4 protein at 3 h as compared to Tubulin control. Right panel: PDCD4 protein levels were quantified relative to Tubulin. C. Cells were treated with 0.5 mM H2O2 for the indicated time points, total RNA was isolated and analysed by qRT-PCR indicating a loss of PDCD4 mRNA as compared to GAPDH control. D. Left panel: HeLa cells were treated with antimiR-21 or a non-targeting antimiR-CTRL (control) for 24 h followed by treatment with 0.5 mM H2O2 for 4 h. Cells were harvested and analysed by western blot analysis. Tubulin was used as a loading control. Right panel: Quantification of PDCD4 levels relative to Tubulin. E. HeLa cells were treated with 0.5 mM H2O2 or PBS and HuR was immunoprecipitated. Bound RNA was isolated and qRT-PCR was performed to determine levels of PDCD4 mRNA. The levels of HuR-bound PDCD4 in PBS-treated cells were set as 1.

H2O2 causes cytoplasmic accumulation of HuR and a loss in PDCD4 expression that is mediated by miR-21A. HuR localization by immunofluorescence of HeLa cells treated with PBS (0 mM H2O2) or 0.5 mM H2O2 for 1 h. Nuclei are visualized by Hoechst staining. Nuclear/Cytoplasmic ratio of HuR is shown on the right. Higher ratio denotes more nuclear staining. B. Left panel: HeLa cells were treated with 0.5 mM H2O2 for the indicated times and cell lysates analysed by western blot analysis indicating a decrease in PDCD4 protein at 3 h as compared to Tubulin control. Right panel: PDCD4 protein levels were quantified relative to Tubulin. C. Cells were treated with 0.5 mM H2O2 for the indicated time points, total RNA was isolated and analysed by qRT-PCR indicating a loss of PDCD4 mRNA as compared to GAPDH control. D. Left panel: HeLa cells were treated with antimiR-21 or a non-targeting antimiR-CTRL (control) for 24 h followed by treatment with 0.5 mM H2O2 for 4 h. Cells were harvested and analysed by western blot analysis. Tubulin was used as a loading control. Right panel: Quantification of PDCD4 levels relative to Tubulin. E. HeLa cells were treated with 0.5 mM H2O2 or PBS and HuR was immunoprecipitated. Bound RNA was isolated and qRT-PCR was performed to determine levels of PDCD4 mRNA. The levels of HuR-bound PDCD4 in PBS-treated cells were set as 1.

HuR directly binds to PDCD4 3'UTR mRNA to regulate its protein expressionA. Left panel: Western blot analysis of PDCD4 protein levels after HuR knockdown. HeLa cells were treated with siHuR or siCTRL (non-targeting control) for 72 h and harvested for western blot analysis. Tubulin was used as a loading control. Right panel: PDCD4 protein levels are quantified relative to Tubulin. B. HeLa cells were treated with siHuR or siCTRL for 72 h, harvested, and total RNA was isolated. PDCD4 mRNA levels were quantified by qRT-PCR and are shown relative to GAPDH mRNA levels. C. Seventy-two hours after siRNA transfection, HeLa cells were treated with 5 µg/ml actinomycin D. After the chase period, cells were processed for qRT-PCR to determine the mRNA half-life (11.6h for siCTRL; 9.5h for siHuR). D. Top panel: HeLa cells were crosslinked with formaldehyde and endogenous HuR was immunoprecipitated with mouse anti-HuR antibody; IgG was used as a control. Western blot analysis shows the level of immunoprecipitated HuR. Bottom panel: HuR-bound RNA was isolated and quantified by qRT-PCR, and is shown relative to IgG-immunoprecipitated material. The levels of GAPDH and RPL13 in HuR immunoprecipitation were determined as specificity controls E. PDCD4 3'UTR RNA was in vitro transcribed, 32P labelled and UV crosslinking was performed with recombinant GST (control) or GST-HuR, separated by SDS-PAGE, and exposed to X-Ray film.

HuR regulates PDCD4 stability via miR-21A. HeLa cells were transiently transfected with a miR-21 mimic for 24 h and cells were harvested for western blot analysis. Tubulin was used as a loading control. B. HeLa cells were transiently transfected with a miR-21 mimic for 24 h and RNA was harvested. qRT-PCR analysis showing decrease of PDCD4 mRNA relative to GAPDH after miR-21 over-expression. C. Left panel: AntimiR-21 or antimiR-CTRL (control) was transiently transfected into HeLa cells for 24 h followed by siHuR transfection for an additional 48 h. Cells were harvested and protein levels were analyzed by western blot. Right panel: Quantification of PDCD4 protein levels relative to Tubulin.

HuR regulates PDCD4 stability via miR-21A. HeLa cells were transiently transfected with a miR-21 mimic for 24 h and cells were harvested for western blot analysis. Tubulin was used as a loading control. B. HeLa cells were transiently transfected with a miR-21 mimic for 24 h and RNA was harvested. qRT-PCR analysis showing decrease of PDCD4 mRNA relative to GAPDH after miR-21 over-expression. C. Left panel: AntimiR-21 or antimiR-CTRL (control) was transiently transfected into HeLa cells for 24 h followed by siHuR transfection for an additional 48 h. Cells were harvested and protein levels were analyzed by western blot. Right panel: Quantification of PDCD4 protein levels relative to Tubulin.

PAGE-MAP (microsphere affinity proteomics) of Rabbit Anti-PDCD4 Antibody. (orb345561). Antibody array western blot binding of gelfree size separated fractions of multiple lysates (solid lines) and shotgun mass spectroscopy identification (dashed lines) of the target band run in parallel correlate confirming the specificity of this antibody against PDCD4.

Western Blot of Rabbit anti-PDCD antibody. Marker: Opal Pre-stained ladder. Lane 1: HEK293 lysate (p/n orb348669). Lane 2: HeLa Lysate (p/n orb348667). Lane 3: MCF-7 Lysate (p/n orb348664). Lane 4: Jurkat Lysate. Lane 5: A431 Lysate (p/n orb348665). Lane 6: Raji Lysate (p/n orb348672). Lane 7: Ramos Lysate. Lane 8: NIH/3T3 Lysate (p/n orb348714). Load: 35 µg per lane. Primary antibody: PDCD antibody at 1:1000 for 3hrs at RT. Secondary antibody: Peroxidase rabbit secondary antibody (p/n orb347654) at 1:30000 for 60 min at RT. Blocking Buffer: 1% Casein-TTBS for 30 min at RT. Predicted/Observed size: 52 kDa for PDCD.

Western blot using Biorbyt's affinity purified anti-Pdcd4 antibody shows detection of a band ~52 kDa in size corresponding to Pdcd4 (arrowhead). Lane 1 contains recombinant Pdcd4. Lane 2 contains 293 HEK cells treated with TPA and MG132. The anti-Pdcd4 antibody was used at a 1: 5000 dilution.
Documents Download
Request a Document
Protocol Information
Pdcd4 Antibody (orb345561)
Participating in our Biorbyt product reviews program enables you to support fellow scientists by sharing your firsthand experience with our products.
Login to Submit a Review